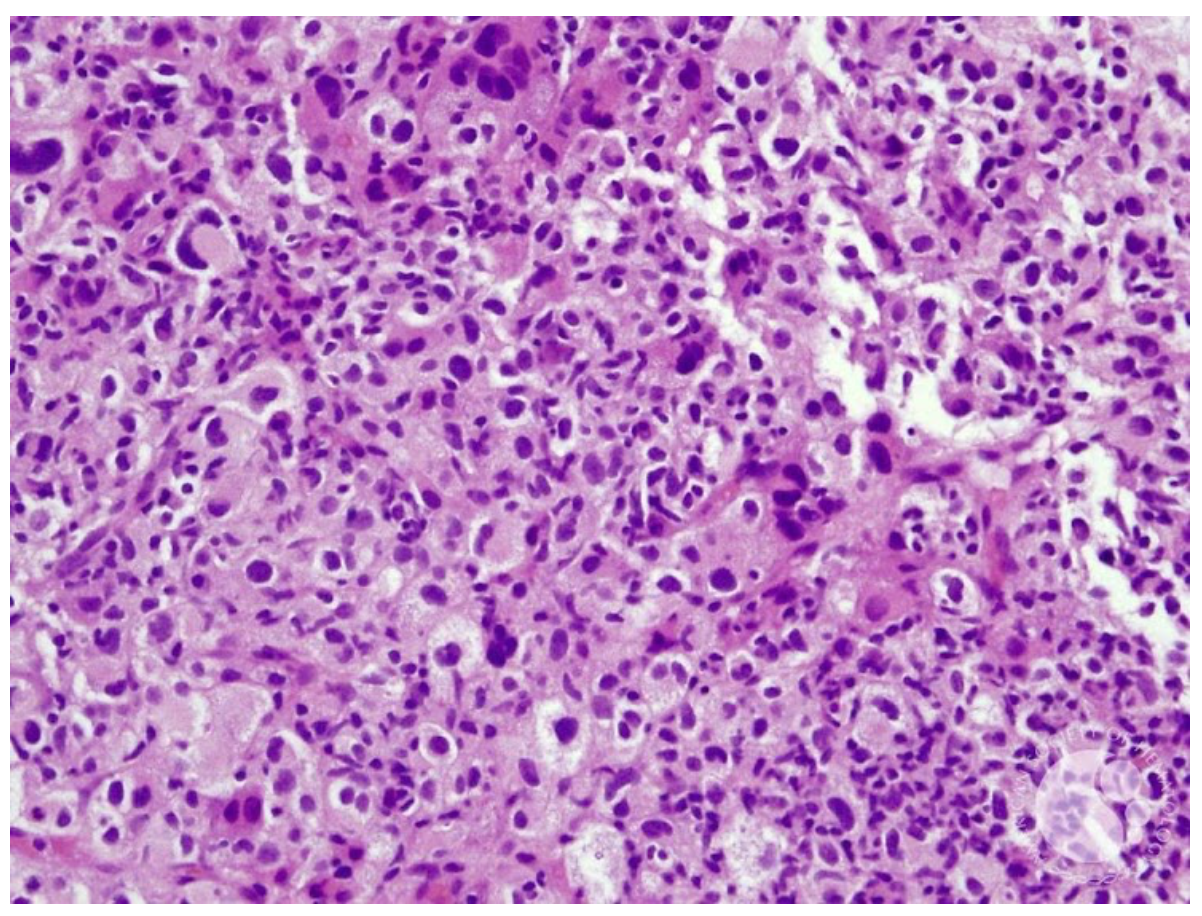
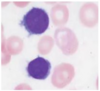
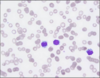
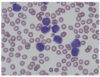

Qual neoplasia linfoide apresenta tipicamente CD5 positivo?
A) Linfoma da zona marginal esplênica
B) Linfoma folicular
C) Linfoma de células do manto
D) Linfoma de Burkitt
LINFOMA DE CÉLULAS DO MANTO
CD5 é uma molécula de superfície que tem efeito regulador inibitório sobre o receptor de célula T (TCR) ou célula B (BCR).
Em indivíduos normais, PREDOMINA em linfócitos T do tipo alfa beta, porém também pode ser identificado em uma subpopulação de linfócitos B, conhecidos como células B-1a.
Essas células são pouco frequentes e estão aumentadas no período neonatal e em doenças autoimunes.
Fora desse contexto, a presença de CD5 em linfócitos B deve ser interpretada como marcador ANÔMALO.
As principais neoplasias de células B que expressam CD5 são:
- Leucemia linfoide crônica; e
- Linfoma de células do manto.
A diferenciação entre essas duas entidades pode ser feita por meio dos marcadores CD23 e CD200, positivos na LLC e negativos no linfoma de células do manto.
Em qual das neoplasias linfoides abaixo NÃO é comum a presença de marcadores para o vírus Epstein-Barr?
A) Linfoma Folicular
B) PTLD
C) Linfoma T/NK extranodal, tipo nasal
D) Linfoma de Hodgkin Clássico, subtipo celularidade mista
LINFOMA FOLICULAR
Várias neoplasias linfoides estão associadas à infecção crônica pelo vírus Epstein-Barr.
Como exemplo clássico temos a forma ENDÊMICA do linfoma de Burkitt, que ocorre em crianças no continente africano (na mesma região endêmica para Plasmodium falciparum) e se caracteriza pela presença de EBV em todos os casos.
Inclusive, o vírus Epstein-Barr foi descoberto em 1964 a partir do estudo de células extraídas do linfoma de Burkitt.
Outro exemplo é o linfoma de Hodgkin clássico, principalmente o subtipo CELULARIDADE MISTA.
Em pacientes com HIV, entretanto, a presença de marcadores para EBV é comum em qualquer subtipo do linfoma de Hodgkin clássico.
A doença linfoproliferativa pós-transplante (PTLD) é outra condição associada à infecção pelo vírus Epstein-Barr e imunossupressão, em pacientes pós-transplante de órgãos sólidos ou transplante alogênico de medula óssea.
O linfoma T/NK extranodal, tipo nasal, também está associado à infecção pelo EBV, podendo-se inclusive utilizar a CARGA VIRAL como marcador de carga tumoral e avaliação de RESPOSTA ao tratamento.
Por fim, os linfomas relacionados ao HIV avançado, como o linfoma primário do sistema nervoso central e o linfoma de efusão primário de serosas também estão associados à infecção pelo EBV.
Key Points:
- O vírus Epstein-Barr está associado a doenças linfoproliferativas, principalmente em indivíduos imunossuprimidos;
- Quando possível, a melhora do estado imunológico é fundamental para controle das doenças linfoproliferativas associadas ao EBV.
A imagem abaixo mostra um corte histológico de biópsia de linfonodo cervical REACIONAL com marcação imunohistoquímica para BCL6. Qual outro marcador apresentaria o MESMO padrão?
A) CD5
B) BCL2
C) MUM1
D) CD10
D) CD10
Nos folículos linfoides SECUNDÁRIOS, as células B naïve entram em contato com o antígeno e sofrem o processo de HIPERMUTAÇÃO SOMÁTICA e TROCA DE CLASSE da imunoglobulina.
Para permitir a ocorrência do processo de SELEÇÃO NEGATIVA das células B cuja afinidade contra o antígeno foi PREJUDICADA após sofrerem hipermutação somática, ocorre DIMINUIÇÃO fisiológica da transcrição de BCL2 (molécula anti-apoptótica) a partir do momento que as células entram no centro germinativo.
Em paralelo, ocorre aumento de expressão das moléculas BCL6 e CD10, típicas dessa fase de maturação.
Portanto, nos folículos linfoides secundários REACIONAIS, a marcação por imunohistoquímica mostra POSITIVIDADE para BCL6 e CD10 e NEGATIVIDADE para BCL2.
Key Points:
- Células B normais dentro do centro germinativo expressam BCL6 e CD10.
No folículo linfoide secundário NORMAL, qual marcador apresenta o seguinte padrão na imunohistoquímica (mostrado abaixo)?
A) CD10
B) BCL2
C) BCL6
D) MUM1/IRF4

B) BCL2
O centro germinativo é a estrutura CENTRAL dos folículos linfoides SECUNDÁRIOS, onde as células B naïve entram em contato pela primeira vez com seus respectivos antígenos, sofrem o processo de expansão clonal e HIPERMUTAÇÃO SOMÁTICA (na zona escura) e TROCA DE CLASSE da cadeia pesada da imunoglobulina (na zona clara).
Após o processo de HIPERMUTAÇÃO SOMÁTICA, a afinidade da célula B por seu antígeno pode melhorar ou piorar.
Caso a hipermutação somática provoque efeito DESFAVORÁVEL na afinidade pelo antígeno, ocorrerá SELEÇÃO NEGATIVA e apoptose da célula.
Para isso ocorrer, é essencial que as vias de apoptose estejam preservadas, o que inclui a inativação da molécula anti-apoptótica BCL2. Qualquer prejuízo nesse processo pode levar à linfomagênese, como é observado no linfoma folicular, que expressa BLC2 inapropriadamente no centro germinativo.
Sendo assim, a pesquisa de BCL2 por imunohistoquímica no linfonodo NORMAL ou REACIONAL mostra padrão típico de coloração POSITIVA nas células da zona do manto (localizada ao redor do centro germinativo e constituídas por células B naïve) e NEGATIVA no interior do centro germinativo.
As poucas células localizadas no interior do centro germinativo que apresentam marcação POSITIVA para BCL2 são na realidade linfócitos T.
Da mesma maneira, as células localizadas no paracórtex e na região interfolicular POSITIVAS para BCL2 também são linfócitos T.
A marcação para CD10 e BCL6 teria padrão inverso, uma vez que ambas são expressas DENTRO do centro germinativo.
Key Points:
- A marcação para BCL2 no linfonodo normal ou reacional marca células B naïve localizadas na zona do manto e células T na região paracortical;
- Células B normais não expressam BCL2 no interior do centro germinativo.
Referências:
- https://www.pathologyoutlines.com/
Qual a alternativa CORRRETA em relação à comparação entre Ibrutinib versus Zanubrutinib no tratamento da macroglobulinemia de Waldenström?
A) Ambos são igualmente eficazes
B) Nenhuma das medicações é eficaz
C) Ibrutinib é mais eficaz
D) Zanubrutinib é mais eficaz
A
A inibição da tirosina quinase de Bruton (BTK) é um tratamento bastante efetivo para a macroglobulinemia de Waldenström (MW).
O estudo randomizado de fase 3 ASPEN comparou a EFICÁCIA e segurança do Ibrutinib (inibidor de BTK de primeira geração) versus Zanubrutinib (inibidor de BTK com maior seletividade) em pacientes portadores de MW sintomática com a mutação do MYD88 L265P.
O desfecho primário foi a taxa de RESPOSTA completa ou resposta parcial muito boa (VGPR).
Como é habitual com o uso de inibidores de BTK, nenhum paciente apresentou resposta completa, apesar de haver melhora importante dos sintomas relacionados à doença.
A taxa de VGPR foi de 28% com uso de Zanubrutinib e 19% com uso de Ibrutinib, sem diferença estatística.
A sobrevida livre de progressão foi de 85% em ambos os grupos, com tempo de seguimento de 18 meses.
A incidência de complicações como fibrilação atrial, diarreia, edema periférico, hemorragia, câimbras, pneumonia e descontinuação da droga por intolerância foi MAIOR no grupo que usou Ibrutinib.
O uso de Zanubrutinib foi associado a maior incidência de NEUTROPENIA, porém sem diferença na incidência de infecções graves.
Para fins diagnósticos, qual a recomendação para pesquisa de rearranjo dos gene MYC, BCL2 e BCL6 no linfoma difuso de grandes células B?
A) Recomenda-se pesquisa somente quando houver expressão de MYC
B) Recomenda-se pesquisa em todos os casos
C) Recomenda-se pesquisa somente no subtipo centro germinativo
D) Recomenda-se pesquisa somente quando houver expressão de MYC ou BLC2
B) RECOMENDA-SE PESQUISA EM TODOS OS CASOS
A presença de rearranjo do gene MYC e BCL2 e/ou BCL6 caracteriza o fenômeno de double hit ou triple hit nos linfomas de células B de alto grau.
A pesquisa dessas alterações citogenéticas é feita por meio de FISH e identifica um grupo de pacientes com PIOR prognóstico, elegível a inclusão em protocolos de pesquisa clínica devido à falta de tratamento padrão adequado.
Conforme a classificação da WHO (Organização Mundial de Saúde), todos os linfomas difusos de grandes células B, linfomas de Burkitt e linfomas de células B de alto grau deveriam ser submetidos à pesquisa desses rearranjos para fins de classificação adequada.
Quando presentes, esses rearranjos definem uma entidade específica denominada “linfoma de células B de alto grau com rearranjo do MYC e BCL2 e/ou BCL6”.
O limitante para realização do FISH é o alto CUSTO.
Além disso, sabe-se que 85% dos linfomas double ou triple hit (DHL/THL) apresentam rearranjo do BCL2 e praticamente todos são do subtipo centro germinativo.
Considerando que cerca de 50% dos casos de linfoma difuso de grandes células B são do tipo centro germinativo, uma estratégia adequada no cenário de limitação de recursos é pesquisar os rearranjos somente neste grupo.
Realizando o FISH exclusivamente no subtipo GCB, podemos identificar 99% dos casos de DHL com rearranjo do MYC e BCL2 e THL (rearranjo do MYC, BCL2 e BCL6).
Entretanto, essa estratégia só consegue identificar 50% dos DHL com rearranjo do MYC e BCL6.
Portanto, sempre que possível, recomenda-se a realização de FISH para todos os casos
Qual situação NÃO é considerada critério de tratamento no linfoma folicular avançado?
A) Derrame cavitário
B) Presença de 3 ou mais lesões >3 cm
C) Massa nodal ou extranodal >7 cm
D) Qualquer lesão extranodal
QUALQUER LESÃO EXTRANODAL
O linfoma folicualr com estadiamento AVANÇADO deve ser tratado somente quando houver doença SINTOMÁTICA ou com ALTA carga tumoral.
Para orientar a decisão clínica, o grupo de estudos francês GELF (Group d’Etude de Lymphoma Folliculaire) validou os seguintes critérios terapêuticos:
- Presença de massa nodal ou extranodal >7 cm;
- Presença de 3 ou mais lesões, cada uma com >3 cm;
- Presença de sintomas B;
- Esplenomegalia volumosa (abaixo da linha umbilical);
- Sintomas compressivos;
- Derrame cavitário (independente do conteúdo celular);
- Presença de >5 mil células neoplásicas circulantes/mm³;
- Presença de citopenias significativas.
A presença de qualquer uma dessas condições indica avaliação quanto a tratamento com terapia sistêmica.
Key Points:
- O linfoma folicular avançado deve ser tratado sempre que houver doença sintomática ou alta carga tumoral, características que frequentemente são observadas de maneira concomitante.
Referências:
- Freedman AR, et al. Initial treatment of stage II to IV follicular lymphoma. Uptodate. 2021.
Qual o gene mutado com MAIOR frequência na micose fungoide?
A) ATM
B) TP53
C) STAT5B
D) STAT3
TP53
Pacientes portadores de micose fungoide/síndrome de Sezary apresentam alta frequência de alterações genéticas complexas, geralmente com aberrações envolvendo os cromossomos 8, 10 e/ou 17 (onde está localizado o TP53).
Também se observam mutações pontuais, sendo a maioria do tipo troca de C por T, que é uma alteração frequentemente provocada pelo dano UVB crônico na pele, mais comum em indivíduos idosos.
Os principais genes alterados, distribuídos conforme o tipo de anormalidade genética são:
- Copy Number Variations (CNV): TP53 (92,5%), seguido pelo ZEB1 (65%) e STAT5B (63%);
- Single Nucleotide Variants (SNV): MLL, seguido pelo TP53, ZEB1 er STAT5B.
Cerca de 92% de todas as driver mutations na MF/SS são desencadeadas pelo mecanismo de CNV, o que torna a mutação do TP53 extremamente frequente. Isso se correlaciona com o comportamento biológico da doença, caracterizado por respostas de curta duração aos esquemas baseados em quimioterapia convencional.
Key Points:
- A elevada frequência de disfunção do TP53 na micose fungoide/síndrome de Sezary se correlaciona com a reduzida eficácia dos tratamentos baseados em quimioterapia citotóxica.
Referências:
- Larocca C, et al. Mycosis Fungoides and Sézary Syndrome: An Update. Hematol Oncol Clin N Am. 2019.
Qual variedade de linfoma de Hodgkin se beneficia da inclusão de RITUXIMAB no tratamento de primeira linha?
A) Linfoma de Hodgkin com predomínio linfocítico nodular
B) Linfoma de Hodgkin clássico, subtipo celularidade mista
C) Linfoma de Hodgkin clássico, subtipo depleção linfocitária
D) Nenhuma
LINFOMA DE HODGKIN COM PREDOMÍNIO LINFOCÍTICO NODULAR
O linfoma de Hodgkin com predomínio linfocitário nodular é raro e corresponde a cerca de 5% dos linfomas de Hodgkin, geralmente acometendo homens de meia idade.
Histologicamente, apresenta células diferentes das células de Hodgkin e células de Reed-Sternberg típicas do linfoma de Hodgkin clássico.
Suas células são denominadas células LP (Lymphocyte Predominant) e são popularmente conhecida como popcorn cells, por seu aspecto convoluto semelhante a uma pipoca.
Diferente do linfoma de Hodgkin clássico, o linfoma de Hodgkin com predomínio linfocitário nodular apresenta POSITIVIDADE para CD20 e NÃO expressa CD30 ou CD15.
O tratamento dos casos com estadio inicial (IA) pode ser feito com RADIOTERAPIA isolada.
Já nos casos com doença AVANÇADA, recomenda-se quimioterapia sistêmica combinada com anticorpo monoclonal anti-CD20 (Rituximab), como as combinações R-ABVD, R-CHOP ou R-Bendamustina.
Key Points:
- Diferentemente do linfoma de Hodgkin clássico, o linfoma de Hodgkin nodular com predomínio linfocitário expressa CD20 e se beneficia da adição de Rituximab ao esquema de quimioterapia convencional nos casos com doença avançada.
- Pacientes com doença inicial (estadio IA) podem ser tratados exclusivamente com radioterapia.
Referências:
- Eichenauer D, et al. How I treat nodular lymphocyte-predominant Hodgkin Lymphoma. Blood. 2020.
Qual fator NÃO está associado a mau prognóstico na micose fungoide?
A) Estadiamento avançado
B) Variante foliculotrópica
C) Elevação de LDH
D) Idade <60 anos ao diagnóstico
IDADE < 60a AO DIAGNÓSTICO
Na micose fungoide/síndrome de Sezary, identificam-se os seguintes marcadores como fatores independentes associados a mau prognóstico:
- Idade avançada ao diagnóstico;
- Estadiamento avançado;
- Variante foliculotrópica;
- Transformação para linfoma de grandes células; e
- Elevação de LDH.
Esses fatores de risco originaram o índice prognóstico recomendado pelo Cutaneous Lymphoma International Consortium study, indicado para avaliação de todos os pacientes com doença avançada.
Neste score, estão contemplados os seguintes fatores:
- Estadio IV;
- Idade maior que 60 anos;
- Transformação para grandes células; e
- LDH aumentado.
Conforme a combinação desses fatores, podemos estratificar os pacientes em três grupos prognósticos, com a respectiva sobrevida mediana em 5 anos:
- Baixo risco: 68%;
- Intermediário: 44%; e
- Alto risco: 28%
Key Points:
- São fatores prognósticos importantes na micose fungoide: idade avançada, estadio avançado, LDH aumentado e transformação para linfoma de grandes células.
Referências:
- Larocca C, et al. Mycosis Fungoides and Sézary Syndrome: An Update. Hematol Oncol Clin N Am. 2019.
No estudo GOYA, qual foi o efeito da TROCA de Rituximab por Obinutuzumab associado ao esquema CHOP no tratamento de primeira linha do linfoma difuso de grandes células B?
A) R-CHOP foi superior a G-CHOP em relação à sobrevida global
B) G-CHOP foi superior a R-CHOP em relação à sobrevida livre de progressão
C) Não houve diferença entre R-CHOP e G-CHOP
D) G-CHOP foi superior a R-CHOP em relação à sobrevida global
NÃO HOUVE DIFERENÇA
O tratamento padrão para o linfoma difuso de grandes células B é o esquema R-CHOP. Entretanto, até 35-40% dos pacientes podem recair após o tratamento de primeira linha.
Por esse motivo, foi estudada a substituição de Rituximab por OBINUTUZUMAB (identificado pela sigla G, baseada no nome comercial Gazyva®).
O Obinutuzumab é um anticorpo monoclonal anti-CD20 completamente humanizado e com maior potência de citotoxicidade direta e citotoxicidade celular dependente de anticorpo quando comparado ao Rituximab.
Estudos em outros cenários, como no tratamento do linfoma folicular, identificaram vantagem na substituição de Rituximab por Obinutizumab.
Com base nisso, foi proposto o estudo de fase III GOYA, com a intenção de comparar os esquemas R-CHOP e G-CHOP no tratamento de primeira linha do linfoma difuso de grandes células B.
Foram randomizados 1418 pacientes, com mediana de seguimento de 48 meses.
Comparando R-CHOP versus G-CHOP, o resultado final identificou a MESMA sobrevida livre de progressão (63% versus 64%) e sobrevida global (78% versus 77%) em 5 anos.
A ocorrência de efeitos adversos foi mais frequentes no grupo que recebeu G-CHOP, com destaque para reações infusionais (10% versus 3%), neutropenia (57% versus 47%) e infecções bacterianas (20 versus 16%).
Key Points:
- No tratamento de primeira linha do linfoma difuso de grandes células B, não há diferença em sobrevida livre de progressão ou sobrevida global em 5 anos quando se compara os esquemas R-CHOP e G-CHOP.
- No grupo que recebeu G-CHOP, houve maior incidência de efeitos adversos.
Referências:
- Sehn LH, et al. Final Analysis of GOYA: A Randomized, Open-Label, Phase III Study of Obinutuzumab or Rituximab Plus CHOP in Patients with Previously Untreated Diffuse Large B-Cell Lymphoma. Blood. 2019.
Qual a alteração genética típica do linfoma Burkitt-like?
A) Aberração do 11q
B) Ganho do 1q
C) t(8;22)
D) t(2,8)
A) Aberração do 11q
O linfoma Burkitt-like com aberração do 11q é um subtipo de linfoma agressivo identificado recentemente, com morfologia e perfil de expressão gênica semelhante ao linfoma de Burkitt, porém SEM rearranjo do gene MYC.
Ao invés disso, essa neoplasia apresenta uma alteração genética característica envolvendo o cromossomo 11q, com GANHO de material genético na região proximal e PERDA na região telomérica.
Esses linfomas NÃO apresentam o típico ganho do cromossomo 1q (frequentemente presente no linfoma de Burkitt clássico), mas apresentam cariótipo complexo com MAIOR frequência.
Morfologicamente, é possível observar maior polimorfismo entre as células e pode haver formação de estruturas semelhantes a folículos linfoides.
Key Points:
- O linfoma Burkitt-like caracteriza-se por aberração do 11q e comportamento clínico agressivo.
Referências:
- The WHO classification of tumors of hematopoietic and lymphoid tissues. 4th revised edition. 2016.
Qual linfoma NÃO está relacionado à infecção crônica pelo vírus da hepatite C?
A) Linfoma da zona marginal esplênica
B) Linfoma linfocítico de pequenas células
C) Linfoma difuso de grandes células B
D) Linfoma linfoplasmacítico
LINFOMA LINFOCÍTICO DE PEQUENAS CÉLULAS
Algumas neoplasias linfoides estão associadas à infecção crônica pelo vírus da hepatite C:
- Linfoma linfoplasmacítico;
- Linfoma difuso de grandes células B;
- Linfoma da zona marginal esplênica;
- Linfoma da zona marginal nodal.
É provável que a infecção viral estimule uma resposta imune sustentada por parte das células B, o que favorece a emergência de clones neoplásicos.
No caso do linfoma da zona marginal esplênica, o tratamento da infecção pelo vírus C pode ser capaz de resolver completamente o processo neoplásico, sem necessidade de tratamento específico.
Key Points:
- São neoplasias linfoides relacionadas à infecção crônica pelo vírus da hepatite C: linfoma linfoplasmacítico, linfoma difuso de grandes células B, linfoma da zona marginal esplênica e linfoma da zona marginal nodal.
Referências:
- The WHO classification of tumors of hematopoietic and lymphoid tissues. 4th revised edition. 2016.
Conforme o estudo RATHL, qual a alternativa INCORRETA em relação ao reestadiamento com PET-CT interim no linfoma de Hodgkin clássico?
A) Pode-se omitir a consolidação com radioterapia se o resultado for negativo
B) Está indicado somente para pacientes com estadio avançado
C) Permite suspender a Bleomicina nos ciclos subsequentes se o resultado for negativo
D) Deve ser realizado 9 a 13 dias após a última sessão de quimioterapia
B) Está indicado somente para pacientes com estadio avançado
O tratamento do linfoma de Hodgkin clássico com o esquema ABVD está associado a altas taxas de cura (70 a 80%), sendo o esquema terapêutico preferencial.
Outro regime mais intenso, o BEACOPP, também apresenta alta taxa de cura e está associado a maior sobrevida livre de progressão em 5 anos (5 a 10% superior) quando comparado ao ABVD, porém às custas de maior TOXICIDADE.
Esse mesmo ganho de sobrevida livre de progressão também é observado quando se escalona a terapia com ABVD para BEACOPP, caso não ocorra resposta adequada à terapia inicial.
Por isso, o estudo controlado e randomizado RATHL avaliou o papel do PET-CT interim no escalonamento ou desescalonamento do tratamento padrão com ABVD em pacientes portadores de linfoma de hodgkin clássico com estadio inicial DESFAVORÁVEL ou estadio avançado.
No total, foram avaliados 1214 pacientes.
Após 2 ciclos de quimioterapia com ABVD, foi realizado reestadiamento com PET-CT entre o 9⁰ e o 13⁰ dia da última sessão de quimioterapia.
Caso o PET-CT fosse negativo (resposta metabólica completa, definida como 1 a 3 pontos no score de Deauville), o tratamento seria desescalonado para AVD, com realização de 4 ciclos adicionais e sem recomendação de radioterapia ao final do tratamento (podendo ser realizada a critério clínico).
Caso o PET-CT interim fosse positivo (score 4 ou 5 de Deauville), a terapia seria ESCALONADA para BEACOPP.
Enquanto isso, o grupo controle realizou 6 ciclos de ABVD, sem ajuste baseado no resultado do PET-CT interim.
Como resultado final, não houve diferença na sobrevida livre de progressão e sobrevida global nos pacientes que realizaram 6 ciclos de ABVD (tratamento padrão) comparado ao grupo que DESESCALONOU o tratamento para AVD após resposta metabólica completa no PET-CT interim.
Por outro lado, houve maior toxicidade PULMONAR no grupo controle, por consequência da maior exposição à Bleomicina.
Key Points:
- O PET-CT interim negativo realizado entre o 9⁰ e 13⁰ dia após 2 ciclos de ABVD pode ser utilizado para desescalonar o tratamento de ABVD para AVD e dispensar consolidação com radioterapia ao final do tratamendo do linfoma de Hodgkin clássico estadio inicial desfavorável ou estadio avançado.
Referências:
- Johnson P, et al. Adapted Treatment Guided by Interim PET-CT Scan in Advanced Hodgkin’s Lymphoma. NEJM. 2016.
Qual dos linfomas abaixo EXPRESSA o marcador BCL6?
A) Linfoma da zona marginal
B) Linfoma folicular
C) Linfoma de células do manto
D) Linfoma linfocítico de pequenas células
LINFOMA FOLICULAR
O marcador BCL6 é uma proteína típica do centro germinativo e, portanto, é observado em linfomas cuja célula de origem encontra-se neste estágio de maturação.
Dessa forma, a expressão de BCL6 é típica do linfoma folicular, linfoma de Burkitt e linfoma difuso de grandes células B, subtipo centro germinativo.
Key Points:
- A expressão de BCL6 pode ser observada no linfoma folicular, linfoma de Burkitt e linfoma difuso de grandes células B, subtipo centro germinativo.
Referências:
- The WHO classification of tumors of hematopoietic and lymphoid tissues. 4th revised edition. 2016.
Qual neoplasia hematológica apresenta hipercalcemia com MAIOR frequência e gravidade?
A) Leucemia/linfoma de células T do adulto
B) Histiocitose de células de Langerhans
C) Doença de Castleman
D) Mieloma múltiplo
A) LEUCEMIA/LINFOMA DE CÉLULAS T DO ADULTO
A leucemia/linfoma de células T do adulto (ATLL) é uma neoplasia altamente agressiva originada de linfócitos T helper periféricos e está etiologicamente associada à infecção crônica pelo vírus HTLV-1.
A doença se manifesta com infiltração cutânea, infecções oportunistas (incluindo pneumocistose) e HIPERCALCEMIA da malignidade.
A hipercalcemia ocorre em 70% dos casos e tem a maior frequência quando comparada a outras neoplasias hematológica, incluindo mieloma múltiplo. Além disso, sua gravidade é maior em relação a outras doenças, frequentemente com valores de cálcio total superiores a 20 mg/dl e complicações neurológicas graves, como o coma.
O mecanismo está relacionado ao aumento do número e da função dos osteoclastos, levando a reabsorção óssea acelerada. Várias citocinas, como IL-1 e TGF-beta, PTHrP e RANK-L fazem parte desse processo.
Key Points:
- A neoplasia hematológica com hipercalcemia mais frequente e mais grave é a leucemia/linfoma de células T do adulto.
Referências:
- Nosaka K, et al. Mechanism of hypercalcemia in adult T-cell leukemia: overexpression of receptor activator of nuclear factor kappaB ligand on adult T-cell leukemia cells. Blood. 2002.
Homem, 25 anos, diagnosticado com linfoma de Hodgkin clássico, subtipo esclerose nodular. Refere febre e sudorese noturna. Estadiamento com PET-CT identificou hipermetabolismo glicolítico superior ao fígado em linfonodo cervical direito (3,0 cm) e linfonodo supraclavicular direito (5,0 cm). Hb 12,0 g/dl, GB 12.000/mm³, Plq 180 mil/mm³ e VHS 25 mm/H. Neste caso, qual o tratamento recomendado?
A) 6 ciclos de ABVD
B) 2 ciclos de ABVD + Radioterapia com 20 Gy
C) 4 ciclos de ABVD + Radioterapia com 30 Gy
D) 4 ciclos de AVD
B) 2 ciclos de ABVD + RT com 20Gy
O tratamento do linfoma de Hodgkin clássico varia conforme o estadiamento inicial e os fatores de risco.
Na doença localizada (estadio I ou II), há preferência por quimioterapia LIMITADA seguida de consolidação com Radioterapia ao final do tratamento, desde que seja possível englobar todas as lesões nodais no mesmo campo de irradiação.
Conforme os critérios utilizados pelo estudo GHSG HD10, que avaliou a elegibilidade a tratamento quimioterápico menos intenso, considera-se como estadio inicial FAVORÁVEL todos os casos com estadio I ou II conforme o estadiamento de Ann Arbor e que NÃO apresentem nenhum dos marcadores de risco adverso:
- VHS maior ou igual a 50 mm/h (ou maior ou igual a 30 mm/h na presença de sintomas B);
- Massa bulky ou grande massa mediastinal (mais de ⅓ do diâmetro torácico);
- Acometimento de >2 regiões nodais;
- Doença extranodal.
O tratamento recomendado para o estadio inicial favorável é 2 ciclos de ABVD seguido de Radioterapia com 20 Gy.
Para o estadio inicial desfavorável, o tratamento recomendado é 3 a 4 ciclos de ABVD seguido de Radioterapia com dose de 30 Gy.
Na doença avançada, o tratamento é feito com 6 ciclos de ABVD, acrescentando-se Radioterapia nos casos com massa bulky conforme avaliação clínica de custo e benefício.
Key Points:
- O tratamento do linfoma de Hodgkin clássico estadio inicial favorável pode ser limitado a 2 ciclos de ABVD seguido de radioterapia na dose de 20 Gy.
Referências:
- NCCN Clinical Practice Guidelines in Oncology. Hodgkin lymphoma. NCCN. 2020.
Qual marcador NÃO é típico do linfoma de células T angioimunoblástico?
A) PD1
B) CD10
C) CD8
D) BCL6
C) CD8
O linfoma de células T angioimunoblástico é uma neoplasia derivada de células T com fenótipo “follicular helper” maduras.
Manifesta-se com quadro sistêmico proeminente, infiltrado linfonodal polimórfico, proliferação das vênulas de endotélio alto e expansão da rede de células dendríticas foliculares.
Caracteriza-se pela expressão de marcadores pan-T (como CD3, CD2 e CD5) e expressão de CD4.
É comum infiltrado reacional rico em linfócitos T CD8, porém este componente celular não deve ser confundido com a neoplasia em si.
Uma característica importante é a expressão de marcadores de células T “follicular helper” (CD10, CXCL13, ICOS, BCL6 e PD1), presentes em 60 a 100% dos casos.
Dentre esses, os mais SENSÍVEIS para o diagnóstico são PD1 e ICOS; e os mais ESPECÍFICOS, CD10 e CXCL13.
Células B EBV positivas estão sempre presentes e constituem parte significativa do infiltrado celular.
Key Points;
- O linfoma de células T angioimunoblástico é um linfoma de células T do tipo CD4 com fenótipo “follicular helper”;
- São marcadores de células T “follicular helper”: CD10, CXCL13, ICOS, BCL6 e PD1.
- É frequente a presença de células B reacionais EBV positivas.
Referências:
- The WHO classification of tumors of hematopoietic and lymphoid tissues. 4th revised edition. 2016.
Homem, 30 anos, usuário de drogas ilícitas, diagnosticado com HIV há 1 ano, porém com recusa terapêutica. Última quantificação de linfócitos T CD4: 32/mm³. Comparece para avaliação devido lesão dolorosa em palato duro com crescimento rápido há 1 mês associada à febre diária, sudorese noturna e perda ponderal. Exame físico e biópsia incisional da lesão mostrados abaixo. Imunohistoquímica: CD45 negativo, CD20 negativo, CD5 negativo, CD10 negativo, CD30 positivo, MUM1 positivo, CD38 positivo, CD138 positivo, CD56 negativo, kappa positivo, lambda negativo, BCL2 negativo, BCL6 negativo, cMYC negativo e Ki67 95%. Pesquisa de EBV por hibridização in situ: positiva. Neste caso, qual o diagnóstico mais provável?
A) Linfoma de Burkitt
B) Mieloma múltiplo
C) Linfoma plasmablástico
D) Linfoma linfoplasmacítico

O linfoma plasmablástico é um linfoma extremamente agressivo caracterizado pela proliferação difusa de grandes células, semelhantes a imunoblastos, porém com marcação NEGATIVA para CD20.
Está relacionado à IMUNODEFICIÊNCIA e tem apresentação tradicionalmente EXTRANODAL, acometendo com frequência a região de cabeça e pescoço e o trato gastrointestinal.
Lesões nodais podem estar presentes em <10% dos casos.
O quadro típico é caracterizado por massa de crescimento rápido em cavidade oral em paciente portador de HIV não tratado e com linfócitos T CD4 abaixo de 50-100/mm³. A presença de doença disseminada (estadio III/IV) é comum ao diagnóstico.
Devido à origem plasmablástica, pode haver componente monoclonal sérico, ainda que não seja obrigatório.
No histopatológico, observa-se infiltrado difuso contituído por células grandes (imunoblastos-like) e células com diferenciação plasmocitária. Figuras de mitose são frequentes.
A presença de EBV pode ser identificada por hibridização in situ e favorece o diagnóstico.
Observa-se expressão de marcadores plasmocitários como CD38, CD138, IRF4/MUM1 e BLIMP1, enquanto os marcadores CD45, CD20 e PAX5 são negativos ou fracos.
Pode haver presença de CD79a em até 40% dos casos.
O marcador anômalo CD56, frequente no mieloma múltiplo, é positivo na MINORIA dos casos (25%) e geralmente está AUSENTE nas lesões da cavidade oral.
Os marcadores EMA e CD30 são POSITIVOS e o índice de proliferação avaliado pelo Ki67 é extremamente alto (>90%), compatível com o comportamento clínico agressivo.
BCL2 e BCL6 são negativos.
Key Points:
- O linfoma plasmablástico é um linfoma agressivo relacionado a imunodeficiência grave e tem apresentação habitualmente extranodal;
- O quadro típico é caracterizado por massa de crescimento rápido em cavidade oral em paciente portador de HIV não tratado;
- CD45, CD20 e PAX5 são negativos. CD38, CD138 e MUM1 são positivos e o Ki67 é >90%;
- A pesquisa para EBV por hibridização in situ é positiva.
Referências:
- The WHO classification of tumors of hematopoietic and lymphoid tissues. 4th revised edition. 2016.
Homem, 49 anos, encaminhado para investigação devido lesão de crescimento rápido em base de língua há 4 meses. Ressonância magnética de cabeça e pescoço confirmou lesão infiltrativa, sem plano de clivagem com as estruturas adjacentes. PET/CT evidenciou hipermetabolismo glicolítico (SUVmáx 16) restrito à cavidade oral. Biópsia incisional foi compatível com SARCOMA HISTIOCÍTICO. Neste caso, qual marcador imunohistoquímico deve estar AUSENTE?
A) CD4
B) CD163
C) CD1a
D) CD68

C) CD1a
O CD1a é uma molécula relacionada ao complexo maior de histocompatibilidade, forma um heterodímero com a beta-2 microglobulina e participa da apresentação de antígenos lipídicos e glicolipídicos para as células T.
A presença de CD1a é típica da histiocitose de células de LANGERHANS, que também expressa a proteína LANGERINA.
Outra doença que também apresenta expressa CD1a é a leucemia linfoblástica de células T com imunofenótipo CORTICAL, que coexpressa CD4 e CD8.
O perfil histoquímico típico do sarcoma histiocítico é CD45 positivo, CD163 positivo, CD68 positivo, lisozima positiva e CD4 positivo.
NÃO há presença de marcadores relacionados à histiocitose de células de Langerhans, como CD1a e langerina.
Key Points:
- CD1a é um marcador típico da histiocitose de células de Langerhans.
Referências:
- The WHO classification of tumors of hematopoietic and lymphoid tissues. 4th revised edition. 2016.
Referências da imagem:
- Ebozue ZL, et al. Histiocytic sarcoma of the base of tongue treated with radical radiotherapy: A case report and review of the literature. Clinical and Translational Radiation Oncology. 2020.
Homem, 52 anos, portador de linfoma folicular grau 1, em seguimento clínico há 4 anos, sem necessidade de tratamento até o momento. Procura atendimento devido surgimento de nódulo de crescimento rápido em parede torácica, febre e perda ponderal. Biópsia da lesão mostrada abaixo. Imunohistoquímica: CD45 positivo, CD19 negativo, CD20 negativo, CD10 negativo, CD3 negativo, CD7 negativo, CD2 negativo, CD5 negativo, CD4 positivo, CD8 negativo, MPO negativo, CD13 negativo, CD33 negativo, CD34 negativo, TdT negativo, HLA-DR positivo, CD163 positivo, CD68 positivo, lisozima positiva, CD1a negativo, CD21 negativo e Ki67 80%. Neste caso, qual a principal hipótese diagnóstica?
A) Linfomas de células T periférico
B) Sarcoma histiocítico
C) Histiocitose de células de Langerhans
D) Linfoma Difuso de grandes células B, rico em células T e histiócitos
B) SACROMA HISTIOCÍTICO
O sarcoma histiocítico é uma neoplasia derivada de células histiocitárias teciduais maduras.
Ocorre geralmente em adultos e pode estar associado a neoplasias linfoides, principalmente linfoma folicular e leucemia linfoide crônica, correspondendo a fenômeno de transdiferenciação.
No anatomopatológico, observa-se infiltrado difuso constituído por grandes células, podendo ser indistinguível do linfoma difuso de grandes células B.
Tem localização EXTRANODAL, mais comum no trato gastrointestinal, pele e partes moles, podendo se manifestar como lesão única ou múltiplas lesões.
Sintomas constitucionais são frequentes e pode haver hepatoesplenomegalia.
O infiltrado é constituído por grandes células, algumas fusiformes, e tem aspecto bastante POLIMÓRFICO.
O citoplasma é eosinofílico, o núcleo excêntrico e a presença de células multinucleadas é comum.
Pode haver infiltrado inflamatório proeminente, podendo inclusive ocultar as células neoplásicas.
Na imunohistoquímica, deve haver expressão de um ou mais marcadores histiocíticos: CD163, CD68 e lisozima.
Devem estar ausentes marcadores de células de Langerhans (CD1a e langerina), células dendríticas foliculares (CD21 e CD35) e células mieloides (MPO e CD13).
Pode haver expressão fraca de CD15.
CD45, CD45RO e HLA-DR também são POSITIVOS.
S100 costuma ser positivo fraco e focal.
CD4 é frequentemente positivo.
Key Points:
- O sarcoma histiocítico é uma neoplasia agressiva caracterizada por células polimórficas;
- A imunohistoquímica tipicamente mostra expressão de CD163, CD68, lisozima e CD4;
- Marcadores definidores de linhagem linfoide e mieloide, células de langerhans e células dendríticas foliculares devem estar ausentes.
Referências:
- The WHO classification of tumors of hematopoietic and lymphoid tissues. 4th revised edition. 2016.
Mulher, 67 anos, internada para investigação de febre de origem indeterminada e perda ponderal. Evoluiu com surgimento de múltiplas telangiectasias e foi submetida a biópsia de pele (mostrada abaixo). Avaliação por imunohistoquímica identificou o seguinte resultado: CD20 positivo, CD5 positivo, CD10 negativo, MUM1 positivo, CD23 negativo, Ciclina D1 negativa, SOX11 negativo, TdT negativo e Ki67 70%. Estadiamento com PET-CT: sem sinais de captação anômala. Baseando-se no diagnóstico mais provável, qual a principal complicação associada?
A) Sindrome Hemofagocítica
B) Infiltração de SNC
C) AHAI
D) Eritrodermia

B) INFILTRAÇÃO DE SNC
O linfoma de grandes células intravascular é uma variante extranodal do LDGCB que cresce dentro de pequenos vasos, principalmente nos capilares, manifestando-se como TELANGIECTASIAS quando acomete a pele.
Ocorre principalmente em idosos (mediana de idade 67 anos) e sua apresentação varia conforme a localização geográfica (Ocidente x Ásia).
A forma clássica, predominante no Ocidente, acomete frequentemente a pele e o sistema nervoso central, responsável pela maior gravidade da doença.
Na Ásia, é comum manifestar-se como síndrome hemofagocítica, SEM lesões cutâneas associadas.
Em ambas as apresentações, febre é o sintoma predominante.
Muitas vezes o estadiamento subestima a carga tumoral pela ausência de massas nodais e o PET-CT pode ser falsamente NEGATIVO.
A realização de biópsia randômica de pele e/ou transbrônquica (pelo acometimento frequente dos capilares pulmonares) é útil para o diagnóstico, um vez que infiltração do tecido subcutâneo é comum mesmo na ausência de lesão visível.
As células linfoides tem tamanho grande e estão localizadas no lumen vascular de diversos órgãos (pele, pulmão, SNC, fígado e baço). Na medula óssea, o padrão de infiltração é intrasinusoidal.
Como todo linfoma difuso de grandes células B, não existe imunofenótipo específico.
O prognóstico é ruim e a principal causa de mortalidade é recaída em SNC, observada em 25% dos casos.
Key Points:
- O linfoma de grandes células intravascular manifesta-se classicamente com febre persistente e telangiectasias;
- O diagnóstico exige alta suspeita clínica e pode ser feito com biópsia randômica de pele e/ou biópsia transbrôquica;
- A infiltração de sistema nervoso central é o principal fator de mau prognóstico da doença.
Referências:
- Freedman AS, et al. Intravascular large cell lymphoma. Uptodate. 2020.
Homem, 62 anos, foi avaliado pela urologia devido aumento indolor de testículo esquerdo e submetido a orquiectomia diagnóstica. Anatomopatológico mostrado abaixo. Imunohistoquímica: CD20 positivo, CD5 negativo, CD10 negativo, BCL6 negativo, BCL2 negativo, MUM1 positivo e Ki67 60%. Hemograma, LDH e bioquímica normal. Estadiamento com PET-CT (realizado após o procedimento cirúrgico): score 2 de Deauville. Avaliação de líquor por citometria de fluxo: ausência de infiltração neoplásica. Foi indicado tratamento com 6 ciclos de R-CHOP. Neste caso, qual terapia complementar deve ser recomendada?
A) Nenhum tratamento adicional
B) Somente radioterapia do testículo contralateral
C) Radioterapia do testículo contralateral + quimioprofilaxia para sistema nervoso central
D) Somente quimioprofilaxia para sistema nervoso central
C) Radioterapia do testículo contralateral + quimioprofilaxia para sistema nervoso central
O LINFOMA PRIMÁRIO DE TESTÍCULO é uma apresentação extranodal RARA, representando 1 a 2 % dos linfomas não-Hodgkin.
A idade mediana é a sétima década de vida e o tipo histológico MAIS COMUM é o linfoma difuso de grandes células B (90% dos casos), seguido do linfoma de Burkitt e do linfoma de Burkitt-like (5 a 10%), geralmente em portadores de HIV.
Nos casos de LDGCB, o subtipo ABC é mais frequente e a presença de mutação do CD79b e/ou do MYD88 são frequentes, o que é um incentivo para ensaios clínicos com Lenalidomida e Ibrutinib no futuro.
Além disso, é comum a amplificação do locus 9p24.1, responsável pela expressão de PD1, sugerindo possível utilidade de inibidores de check-point imunoklógico no tratamento de resgate desses casos.
A apresentação clínica típica é como massa testicular unilateral indolor, podendo haver tumor sincrônico (10% dos casos) ou metacrônico (30%) no testículo contralateral.
Habitualmente, o testículo acometido é RETIRADO para permitir o diagnóstico.
Independente do estadiamento, recomenda-se tratamento SISTÊMICO baseado em R-CHOP (6 ciclos) associado a PROFILAXIA para sistema nervoso central (com quimioterapia intratecal e/ou sistêmica) e RADIOTERAPIA do testículo contralateral
Mesmo com realização de profilaxia adequada, a taxa de RECIDIVA em sistema nervoso central é elevada.
Key Points;
- O linfoma primário de testículo tem como principal histologia o linfoma difuso de grandes células B, subtipo ABC;
- Mutações no CD79b e no MYD88 são frequentes, assim como a amplificação do 9p24.1 (PD1);
- O tratamento é baseado em orquiectomia diagnóstica, quimioterapia sistêmica (6 ciclos de R-CHOP), quimioprofilaxia para sistema nervoso central (intratecal e/ou sistêmica) e irradiação testicular contralateral.
Referências:
- Educational Updates in Hematology Book. 25th Congress of the European Hematology Association. 2020.
Homem, 58 anos, encaminhado para avaliação após realizar biópsia incisional de nódulo ulcerado em região axilar esquerda. Anatomopatológico mostrado abaixo (A, H&E; B, CD3; C, CD30; e D, ALK). FISH para pesquisa de t(2;5) resultou positivo. Hemograma, LDH e demais exames laboratoriais normais. Estadiamento com PET-CT identificou hipermetabolismo glicolítico restrito à região axilar esquerda. Neste caso, qual o diagnóstico mais provável e o tratamento indicado?
A) Linfoma anaplásico de grandes células primário cutâneo; Observação clínica
B) Linfoma anaplásico de grandes células primário cutâneo; Radioterapia local
C) Linfoma anaplásico de grandes células; Tratamento com CHOEP
D) Linfoma anaplásico de grandes células; Tratamento com BV-CHP

D) Linfoma anaplásico de grandes células; Tratamento com BV-CHP
O linfoma anaplásico de grandes células é um tipo de neoplasia T nodal constituída por células grandes, com citoplasma abundante e núcleo irregular, assumindo formatos bizarros muitas vezes semelhantes a ferradura ou rim.
A principal característica desse linfoma é a expressão homogênea e forte de CD30, com marcação em citoplasma e complexo de Golgi.
Outra característica importante (mas nem sempre presente) é a hiperexpressão do gene ALK por consequência de rearranjos envolvendo o cromossomo 2, sendo a t(2;5) a mais frequente (75% dos casos). Quando presente, correlaciona-se com melhor prognóstico.
Marcadores associados à linhagem T como CD2, CD5 e/ou CD4 costumam estar presentes, assim como TIA1, granzima B, perforina, CD45, CD45RO, CD61 e CD25.
Em até 25% dos casos, pode haver perda de expressão de CD3, o que pode gerar dificuldade no diagnóstico inicial.
A ausência de PAX5 e CD15 é um dado importante no diagnóstico diferencial com linfoma de Hodgkin, uma vez que podem estar presentes células Reed-Sternberg-like.
Existe uma variante do linfoma anaplásico de grandes células restrito à pele (primário cutâneo) cujo prognóstico é bom e muitas vezes não exige tratamento sistêmico. O diagnóstico é confirmado após estadiamento completo, com exclusão de lesões extracutâneas. Nessa entidade, porém, raramente se observa rearranjo do gene ALK.
Conforme os dados do estudo ECHELON-2, o esquema baseado em Brentuximab vedotina é superior ao tratamento tradicional com CHOP para pacientes com linfoma T e expressão de CD30 maior ou igual a 10%.
Portanto, o melhor tratamento disponível seria a combinação BV-CHP (Brentuximab + Ciclofosfamida + Doxorrubicina + Prednisona), lembrando que a vincristina não deve ser combinada com Brentuximab vedotina pelo efeito aditivo de neuropatia periférica.
Key Points:
- O linfoma anaplásico de grandes células caracteriza-se pela expressão forte e homogênea de CD30;
- A principal translocação associada à hiperexpressão do ALK é a t(2;5);
- A variante do linfoma anaplásico de grandes células primário cutâneo raramente apresenta hiperexpressão do gene ALK;
- Nos linfomas T CD30 positivos, a combinação BV-CHP é superior ao tradicional CHOP.
Referências:
- Jacobsen E, et al. Treatment of systemic anaplastic large cell lymphoma. Uptodate. 2020.